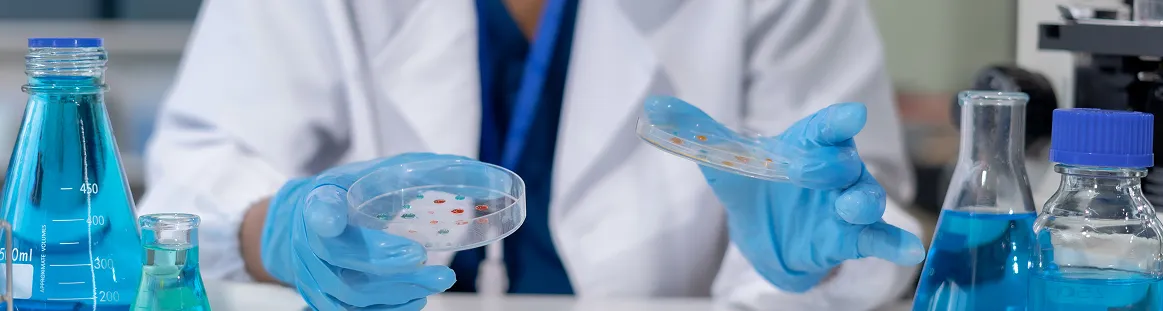
Results Image

Where depth meets detail

At Trupeak, we go far beyond standard testing. We measure more than 800 health markers across all major body systems to create a complete picture of your health from day one.


By detecting small imbalances early, we can address them before they turn into symptoms. Our approach reveals underlying issues such as elevated stress hormones or poor nutrient absorption, providing the foundation for a truly personalised care plan from the start.
Every result is reviewed in context of your lifestyle, medical history, and goals, with a focus on patterns that track progress or reveal early warning signs.
Care is guided by clear, evidence-driven insights that support recovery, resilience, and long-term balance, never assumptions.
Use this email for documentation, scheduling follow-ups, etc.
Call us to connect with our front desk or care coordinator.
Trupeak Health, Suite A/405, Kohinoor Square, Shivaji Park, OPP Shiv Sena Bhavan, Dadar West, Mumbai - 400028
Monday to Sunday:
9:00 AM – 9:00 PM
We’re here to support your journey
to optimal health.